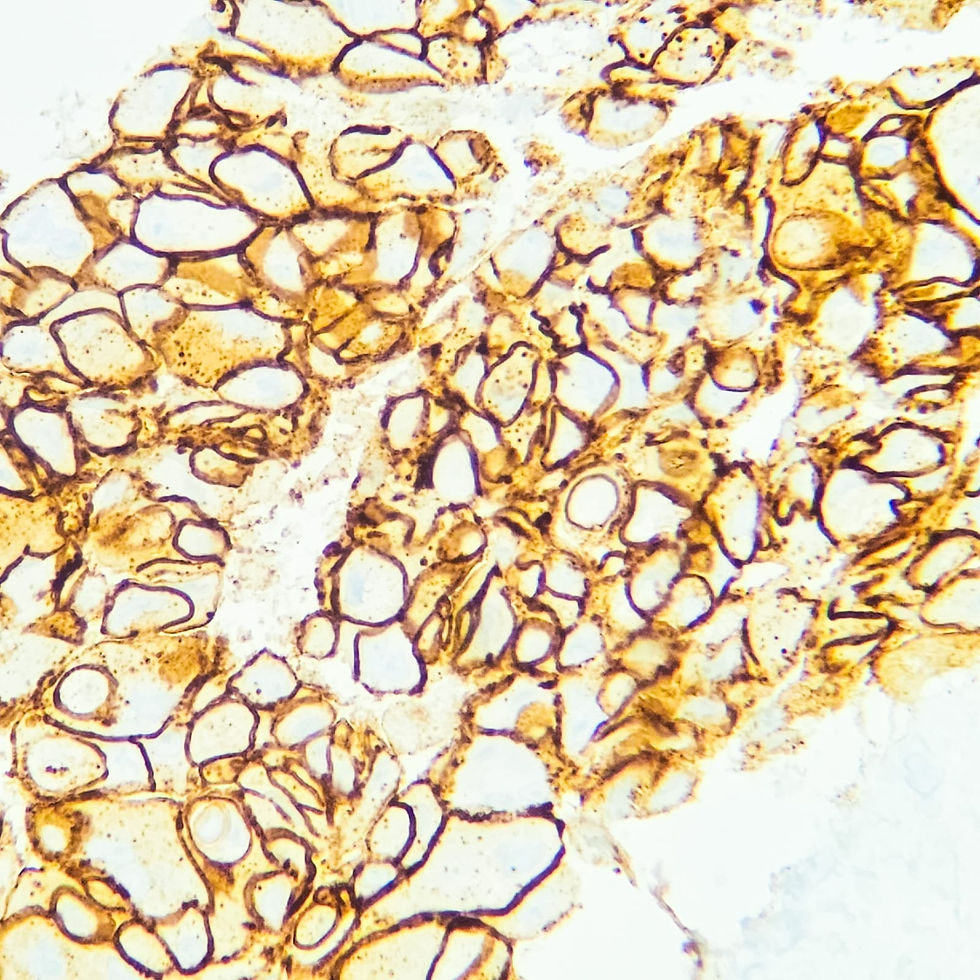

Servicios
Galería

Sobre Nosotros
Bienvenido al Laboratorio de Patología, Dra. Teresa Barrios en Veracruz, donde ofrecemos resultados precisos en solo 5 días hábiles*. Nuestros informes son confiables y detallados, con atención personalizada para discusiones de casos.
Análisis
Nuestros análisis patológicos abarcan una amplia gama de pruebas para garantizar diagnósticos precisos y oportunos. Contamos con tecnología de vanguardia y un equipo médico altamente capacitado.
.jpg)
Resultados Rápidos
Entrega en 5 Días hábiles*
En Laboratorio de Patología, Dra. Teresa Barrios, nos comprometemos a entregar resultados confiables en un plazo de 5 días hábiles. Priorizamos la eficiencia sin comprometer la calidad de nuestros informes.
*Consulte política de entrega

Atención Personalizada
Discusión de Casos
Ofrecemos atención directa para discutir casos específicos y brindar soluciones personalizadas. Nuestro equipo médico está disponible para responder a tus consultas y proporcionar orientación experta.

Informes Detallados
Imágenes de Microscopía
Nuestros informes incluyen imágenes detalladas de microscopía para respaldar nuestros diagnósticos. Esta visualización facilita la comprensión de los resultados y garantiza una interpretación precisa.